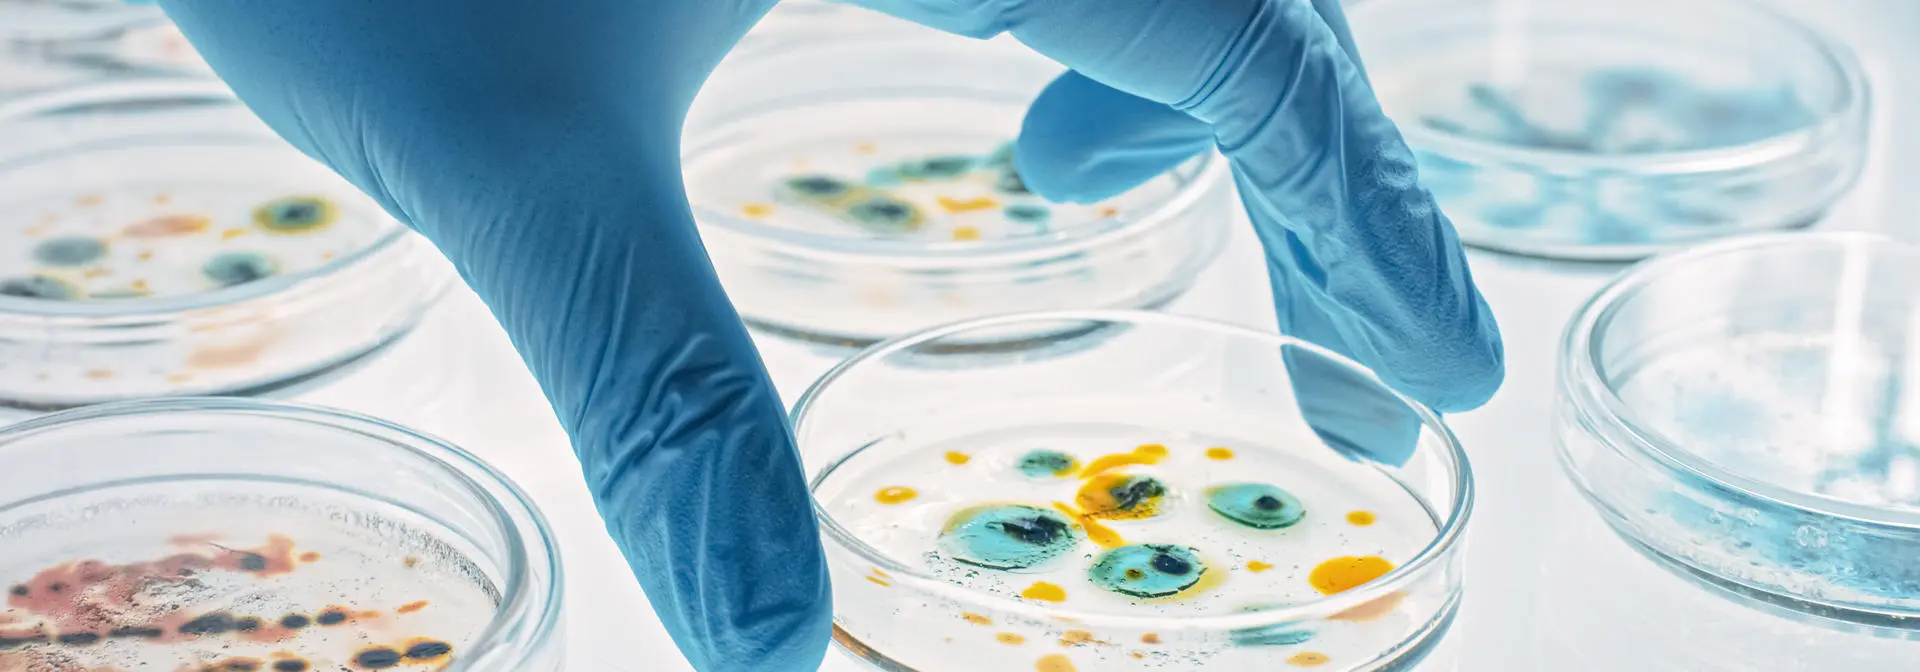

Health and Care Technologies
The establishment of the Global Research Institute in Health and Care Technologies aims to expedite the advancement of research, facilitating the swift integration of new technologies. Collaborating with industry, stakeholders, fellow academics and charities, we are dedicated to addressing significant global health challenges. Our goal is to deliver innovative, sustainable and user-inspired solutions through a co-creative approach.
Operating across campuses in Scotland, Dubai, and Malaysia, we partner with the health and care industry worldwide. Utilising our world-class facilities, we focus on developing new diagnostic tools and treatments, leveraging our expertise in research and engineering in collaboration with existing global research institutes.
Our initiative extends beyond research, as we actively bridge the gap from bench to bedside through the creation of spin-out companies. Additionally, we play a crucial role in influencing national policy decisions, supporting the growth of the next generation workforce, and fostering a collegiate, collaborative, and supportive academic community.
Our mission is to develop innovative solutions to the most pressing health challenges of our time, including cancer, chronic diseases, mental health, and global health threats, with a particular focus on improving patient care and health outcomes across the globe. Through a multidisciplinary and collaborative approach, we combine the expertise of engineers, healthcare professionals, and researchers to push the boundaries of what's possible in health and care innovation.

Global Research Institute in Health and Care Technologies
Learn more about the institute.

Prolonging life independence in healthy ageing
Find out more about our work in enhancing the lives of older adults

Global Research Institute in Health and Care Technologies - Dubai
Discover how researchers based at our Dubai campus are driving global impact health and care.
Our projects

Harnessing technology to help people with dementia remain at home
A new network focusing on how technology can enhance the social, mental and physical capacities of people with dementia.

People living with dementia can be powerful design collaborators, new Heriot-Watt research shows
People living with dementia should have more power and creative freedom in collaborative design projects, new research from Heriot-Watt University suggests.

Robots help guide self-managed rehabilitation for stroke and brain injury survivors
Robots aiding upper limb rehabilitation for stroke and brain injury survivors have been successfully trialled in Vienna, Austria by researchers from the National Robotarium.
Our new GRI in Health and Care Technologies unites a diverse community across our global network, delivering use-inspired solutions. We operate at the intersection of healthcare, engineering, and social sciences, co-developing innovations with patients at the heart of the process. By integrating expertise across disciplines, we're committed to making a lasting impact on health and social care challenges.Professor Steve McLaughlin, Vice Principal and Provost
Get in touch
Heriot-Watt’s Global Research Institutes (GRIs) are centres of excellence and collaboration, created to address global challenges by leveraging our global reach, our significant international collaborations and our long-standing connectivity to business and industry.
Professor Richard A. Williams, Principal and Vice-Chancellor
Together, we shape the future.
Since 1821 we have been at the forefront of new ideas and solutions, creating radical innovations that make a difference in the real world. Heriot-Watt has an established reputation as a dynamic facilitator of successful strategic alliances. The University aims to solve problems of real significance to society by excelling in business and enterprise.